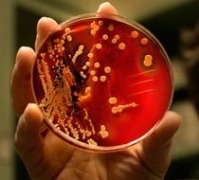

Главная
Новости стерилизации…
Новости стерилизации и дезинфекции
-
Открытие основных генов резистентных штаммов бактерий поставило перед разработчиками лекарственных средств новые цели
-
Принимаются заявки на соискание премии Heroes of Infection Prevention Award на 2013 год
-
7-ая жертва Klebsiella pneumoniae в Клиническом центре Национального Института Здоровья, США
-
Исследователи нашли новые препараты, не содержащие антибиотиков, которые эффективны против MRSA и обычных стрептококковых инфекций
-
90 лет Роспотребнадзору!
-
Фальсифицированный стерилизатор пытались поставить в «Городской родильный дом № 1» Липецка
Арбитражным судом города Санкт-Петербурга и Ленинградской области принято решение по делу № А56-14855/2012 о поставке фальсифицированного стерилизатора парового ГП-400-1. Общество с ограниченной…